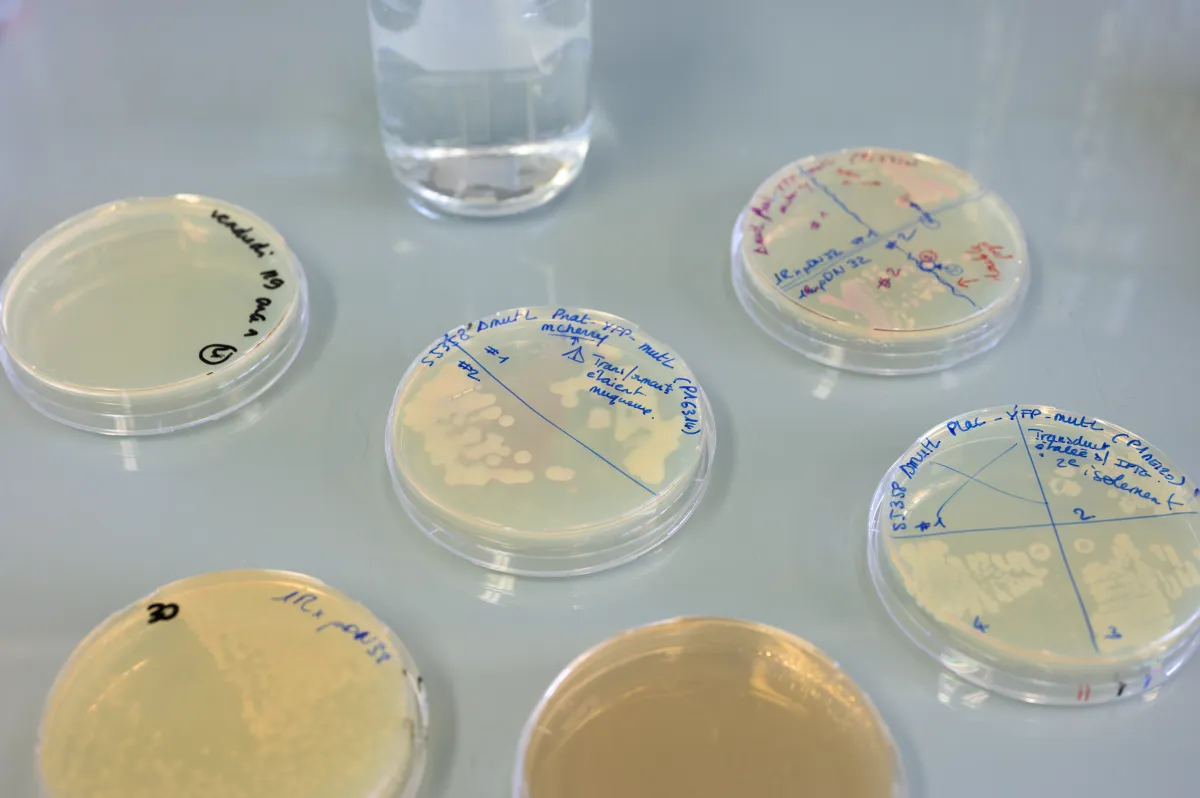
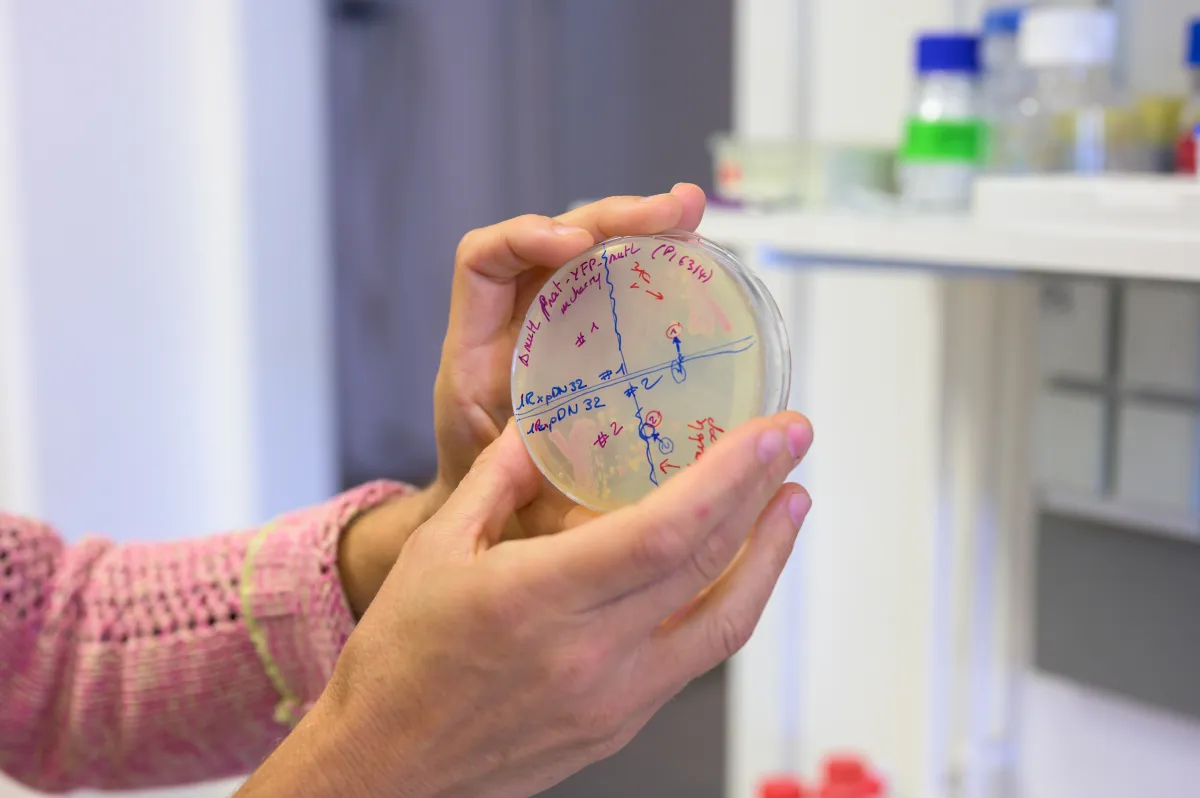

Lydia Robert Measuring the mutation rate of bacteria
Lydia Robert, co-director of the single cell mutagenesis and evolution team, Micalis Institute, INRAE, Jouy-en-Josas, France
- 2022 • Impulscience



Why are bacteria becoming increasingly resistant? Many researchers have tried to answer this question, without being able to fully resolve the enigma. Lydia Robert and her team are using a new multidisciplinary method to determine, for the first time, the environment’s impact on the appearance of mutations in bacteria DNA at the origin of the phenomenon.
An "arms race" in our bodies
A strange arms race is constantly underway in our bodies. It is a fight between our resistance to infectious diseases and the pathogens themselves. Mutations are the basis of this internal war, that allow pathogens to evolve. For example, they can enable them to develop greater resistance to antibiotics, or make them more virulent. Similarly, some cancer cells accumulate mutations that allow them to escape chemotherapy. However, environmental factors also induce mutations. For example, sublethal doses of antibiotics seem to promote mutagenesis in bacteria.
A pioneering new method
However, these results are controversial. Classic experiments have limitations and are prone to bias. Dr. Robert and her colleague Marina Elez have developed a groundbreaking method to overcome those hurdles. They use a single-cell approach to accurately characterize mutagenesis in Escherichia coli bacteria in different environments. They combine genetics, molecular biology, microfluidics, optogenetics, deep sequencing, mathematical modeling, statistics and other disciplines to achieve the best results.
The Foundation’s support
The support from Fondation Bettencourt Schueller will allow Dr. Robert to clear the obstacles of the traditional experimental approach. Her main goal is to define the environment’s impact on the bacterial mutation rate for the first time. She plans to study the effects of limiting the nutrients provided to the bacteria and adding sublethal doses of antibiotics. The idea is also to understand the impact of transient mutation rate variations on the evolution of bacteria, especially the emergence of resistance to antibiotics. In addition to being a key contribution to this field of research, the findings could have clinical implications as antibiotic resistance becomes a major health issue.
Lydia Robert in a few words
After her multidisciplinary studies at the Ecole Polytechnique, Lydia Robert turned to microbiology. In 2010, she obtained a PhD in life and health sciences at the Hôpital Necker Enfants Malades, in Paris. During her PhD work, she developed powerful microfluidic tools to observe the development of bacteria dynamically under controlled conditions on the scale of a cell and over the long term for the first time. She then immediately obtained a research position at INRA’s Micalis Institute, where she now co-leads the single cell mutagenesis and evolution team. Using a multidisciplinary approach, she has contributed many pioneering approaches and tools to her field.

Impulscience
Impulscience allocates 7 new grants each year to researchers in the life sciences. Focused on the mid-career, this program aims to support this crucial stage for the development of research projects.
All the award-winnersCall for applications
Online applications open on 7 April 2026 and close on May 21, 2026 for candidates who responded to ERC Starting or Consolidator 2025 calls ; on June 22, 2026 for candidates who responded to ERC Advanced 2025 call.